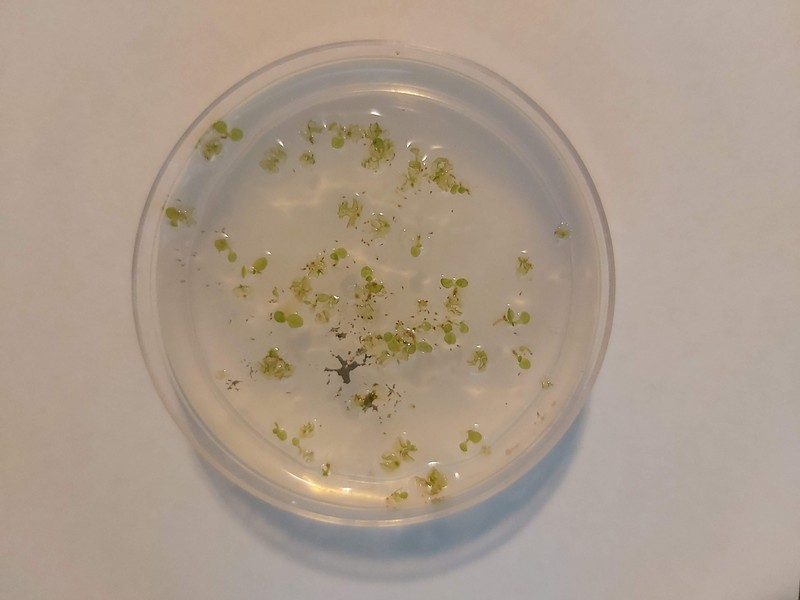
Triangle Waterfern

Triangle Waterfern
Ceratopteris richardii
Taxonomy
- Division:
- Pteridophyta | - Ferns
- Family:
- Pteridaceae
- Genus:
- Ceratopteris
- Species:
- Ceratopteris richardii
Growth Characteristics
- Life Cycle:
- Annual
- Growth Habit:
- Forb/herb
- Height:
- 4-6 ft
- Light Requirements:
- Part Shade
- Drought Tolerance:
- High
- Bloom Colors:
- Not Applicable
Native Range
United States: Alabama, Louisiana, Puerto Rico
Soil Requirements
- Soil Type:
- rich, well-drained loamy soil
- pH:
- 5.5 - 7.0 (slightly acidic to neutral)
- Drainage:
- tolerates poor drainage
- Moisture:
- consistently moist
- Notes:
- Commonly found in aquatic or semi-aquatic environments